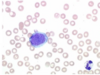

How do we lose fluid?
Urine
Faeces/diarrhoea
Vomit
Blood loss
Third space loss (body cavities)
Inflammatory exudate
Insensible losses
- e.g. sweating & breathing (fluid lost but only to a small degree)
What are the 3 major compartments within the body where fluid is stored

Define dehydration and give an example

Define hypovolaemia and give an example

What are the signs of hypovolaemia

What are the signs of dehydration

Define shock

What are the 4 types of shock

Label the types of shock


How can we recognise the 4 types of shock

Gives some signs of fluid loss, clinical signs and reason in cattle


Gives some signs of fluid loss, clinical signs and reason in dog/cat


What are the types of fluids
Crystalloids
- isotonic, hypertonic & hypotonic
Colloids
Transfusion products
Describe isotonic fluids
Used for fluid resuscitation
for both hypovolaemia & dehydration
they equilibrate across membranes rapidly to restore both intravascular & extravascular spaces
effect on intravascular volume expansion can be shirt lived
Give examples of isotonic fluids
Hartmann’s:
- contains sodium, chloride, potassium, calcium, lactate +- magnesium
- useful in most patients
- esp. metabolic acidosis
sodium Chloride (saline):
- 0.9% sodium chloride only
- less balanced in terms of electrolytes & quite acidifying
Dextrose solutions (D5W):
- 5% glucose in 0.18% saline
- dangerous fluid type because glucose is rapidly metabolised leaving 0.18% sodium chloride which is basically water & thus hypotonic
- dont use, if you need glucose supplementation add glucose to saline or Hartmanns
Give examples of hypertonic fluids
Saline in various strengths (usually 7.2%)
- draws fluid into intravascular space (only use IV)
- fluid drawn from interstitial space so dont use in dehydrated patients
- works rapidly (useful for hypovolaemic shock)
- low volumes required so useful for large animals
- draws fluid from brain so useful in head trauma
- sodium can be dangerous so only use 1/2x per 24h & always follow with isotonic fluids
Give examples of hypotonic fluids
usually saline (0.45% NaCl)
- rarely used
- main use would be hypernatraemia (high sodium in blood) to dilute it
- be careful how quickly you reduce hypernatraemia
* sodium balances across BBB
* if you drop Na quickly –> osmotic gradient into brain –> flood brain causing cerebral oedema
Describe colloid fluids
controversial
contain macromolecules which mimic albumin (protein) in blood to provide oncotic pressure
should provide constant buff to intravascular volume by helping retain fluid
but has been shown to increase risk of death & acute kidney injury in dogs
Describe transfusion products

What are the routes for fluid administration
intravenous
- rapid & continuous
* useful for dehydration & hypovolaemia
Intraossesous
- almost as fast as IV but difficult to place & complications (rare) can be severe
- isotonic fluids only
Subcutaneous
- reliant on good subcutaneous blood supply to redistribute fluid so only for mild dehydration
Oral
- relies on functioning GIT
- often used in LA
- can be combined with nutrition via feeding tubes
- use isotonic
- too much water is bas
Rectal
- effective in horses
- only for dehydration & not in diarrhoea
Intraperitoneal
- reliant on good peritoneal blood supply
- can be painful
- rarely used